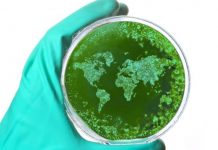
Emiten alerta epidemiológica en India por brote del virus Nipah

Un taquero mexicano fue hospitalizado en la India después de probar comida callejera en un puesto insalubre, informaron medios locales este sábado.
El hombre aceptó la propuesta del ‘tiktoker’ HotSpanish para viajar a la India y probar comida callejera. Recientemente, se ha difundido información en Internet sobre la falta de salubridad e higiene en esos alimentos que se venden en el país asiático.
En un video publicado en redes sociales, se observa cómo el taquero es invitado por HotSpanish a viajar a la India para una degustación gastronómica en las calles, con la tentadora oferta de ganar un coche último modelo. A pesar de las dudas iniciales, el taquero aceptó la propuesta con la esperanza de que HotSpanish le regale el vehículo para ayudar a expandir su negocio.
Acompañado por un integrante del equipo del ‘tiktoker’, el taquero visitó un puesto de comida callejera en el que supuestamente Óscar Curi, un ‘influencer’ peruano, falleció tras consumir alimentos en mal estado a finales del mes pasado.
“¡No mames, carnal, ¿dónde me trajiste? Ve, el señor recoge la comida del suelo y la vuelve a echar a la olla. Estoy bien nervioso, la neta se ve bien asqueroso”, expresó el taquero. Después de ingerir el alimento, el taquero empezó a sentir malestar, palidez y sudoración, por lo que fue trasladado de urgencia a un hospital cercano.
“Mírame, hasta se me puso chinita la piel y estoy sudando, quiero vomitar. No más por respeto a la gente y a los clientes que estaban ahí, pero también tengo una taquería y ¿tú crees que me va a gustar que alguien llegue y vomite al ver la comida que vendo?”, se quejó el mexicano después.
Finalmente, el taquero se recuperó y recibió su premio, aunque algunos usuarios en redes sociales criticaron a HotSpanish, señalando que obliga a personas de escasos recursos a realizar este tipo de desafíos.